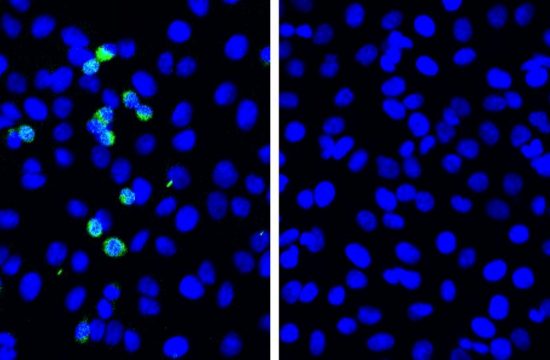
sars cov 2 virtal sipike proteins green

deepai Gravity feels reliable — stable and consistent enough to count on. But reality is far stranger than our intuition. In truth, the strength of gravity varies over the Earth’s surface. And it is weakest…
Novel defense mechanism for SARS-CoV-2 discovered
Scientists from Hokkaido University have discovered a novel defensive response to SARS-CoV-2 that involves the viral pattern recognition receptor RIG-I. Upregulating expression of this protein could strengthen the immune response in COPD patients. In the…
Nonprofits, Government Surpass Pharma in Alzheimer’s Drug Development
Two articles published by Alzheimer's & Dementia: Translational Research & Clinical Interventions show substantial changes in the focus and funding of clinical trials for Alzheimer's disease therapies. The newly published articles throw a greater spotlight on a…
NASA Schedules Live Coverage of Russian Spacewalk
Two Russian cosmonauts are scheduled to conduct a spacewalk outside the International Space Station Wednesday, June 2, to continue preparing the Pirs docking compartment airlock for undocking and disposal later this year. Live coverage will begin at…
LU and SZU sign Letter of Intent on…
Lingnan University (LU) and Shenzhen University (SZU) signed a Letter of Intent(LOI) on Collaboration to foster academic cooperation in various areas on 25th May, 2021. Andrew Yao Cho-fai, Council Chairman of Lingnan University and Li Qingquan, President of Shenzhen…